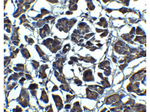
IL-23 Antibody in Immunohistochemistry (Paraffin) (IHC (P))

Search
Rockland
IL-23 Polyclonal Antibody
{{$productOrderCtrl.translations['antibody.pdp.commerceCard.promotion.promotions']}}
{{$productOrderCtrl.translations['antibody.pdp.commerceCard.promotion.viewpromo']}}
{{$productOrderCtrl.translations['antibody.pdp.commerceCard.promotion.promocode']}}: {{promo.promoCode}} {{promo.promoTitle}} {{promo.promoDescription}}. {{$productOrderCtrl.translations['antibody.pdp.commerceCard.promotion.learnmore']}}
图: 1 / 7
IL-23 Antibody (600-401-G99) in ICC/IF

产品信息
600-401-G99
种属反应
宿主/亚型
分类
类型
抗原
偶联物
形式
浓度
规格
纯化类型
保存液
内含物
保存条件
运输条件
靶标信息
IL-23 is a heterodimeric cytokine composed of the p40 subunit of IL-12 disulfide-linked with a protein p19. p19, like p35 of IL-12, is biologically inactive by itself. IL-23 interacts with IL-12Rbeta1 and an additional, novel beta2-like receptor subunit with STAT4 binding domain, termed IL-23R. IL-23 is secreted by activated mouse and human dendritic cells. Biological activities of mouse IL-23 are distinct from those of mouse IL-12. Mouse IL-23 was found not to induce significant amounts of IFN-γ. Mouse IL-23 does induce strong proliferation of memory T cells (but not naive T cells), whereas IL-12 has no effect on memory cells. Additionally, mouse IL-23 (but not IL-12) can activate mouse memory T cells to produce the proinflammatory cytokine IL-17. Human IL-23 has biological properties which are less distinct from human IL-12; human IL-23 induces proliferation of memory T cells and induces moderate levels of IFN-γ production by naive and memory T cells, as compared to IL-12.
仅用于科研。不用于诊断过程。未经明确授权不得转售。
篇参考文献 (0)
生物信息学
蛋白别名: il 23; IL 23 A; Il-12b; Il-12p40; IL-23 subunit alpha; IL-23-A; IL-23p19; IL12B; Il12p40; il23; ILN; Interleukin; interleukin 12B; interleukin 23 p19 subunit; interleukin 23, alpha subunit p19; Interleukin-23 subunit alpha; Interleukin-23 subunit p19; interleukin-six, G-CSF related factor; JKA3 induced upon T-cell activation; MGC79388; p40; RP23-388G23.1
基因别名: IL-23; IL-23A; IL23A; IL23P19; P19; SGRF; UNQ2498/PRO5798
UniProt ID: (Human) Q9NPF7, (Mouse) Q9EQ14
Entrez Gene ID: (Human) 51561, (Mouse) 83430




